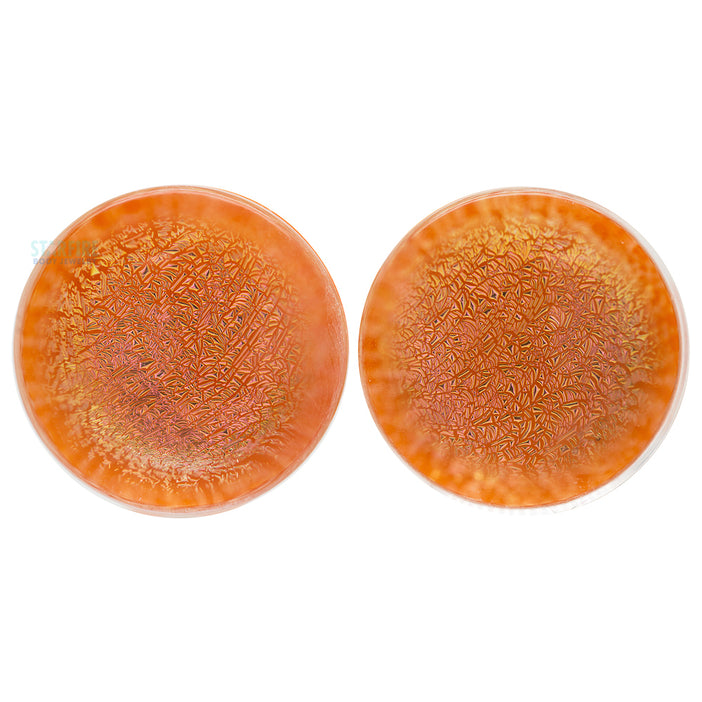

JEWELRY - Plugs & Eyelets
From starter sizes to the committed stretcher, we carry a large variety of high-quality plugs and eyelets. Glass plugs are a great option to stretch with, but then you should find a great pair of wood or stone plugs to change out to. If you’re looking for some comfy plugs, there is no better option than silicone eyelets. Speaking of eyelets, if your goal in stretching your lobes is to see through them, make sure to shop the variety we’ve hunted down for you.
Starfire Body Jewelry only carries the best in basic and unique jewelry from the best brands in the industry. Rest assured that we will never carry any knock-off plugs or poorly made big gauge jewelry.